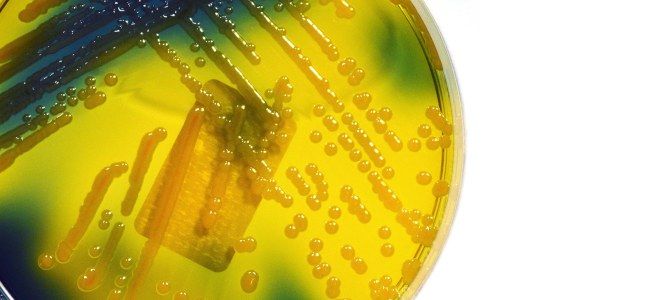
Клебсиелла пневмония в кале Клебсиелла пневмония в кале

Клебсиелла пневмония – условно патогенный микроорганизм, который не представляет опасности для здоровья человека. Риск развития какого-либо заболевания и появления его симптомов возникает, если у пострадавшего снижен иммунитета. Присутствие клебсиеллы в мазке цервикального канала – тревожный признак, который может указывать на развитие воспалительного процесса. Какое влияние на организм человека оказывает бактерия? Почему инфицирование опасно в период беременности? Какие симптомы могут свидетельствовать об инфицирование? Какие препараты обеспечивают уничтожение бактерии? Ответы на все приведенные вопросы читатели получат из статьи.
Что такое клебсиелла пневмония
Клебсиелла имеет принадлежность к семейству энтеробактерий, она неподвижна. Может расти в анаэробной и бескислотной среде, лишена спор и жгутиков. Сопротивляемость микроорганизма к антителам и антибиотикам высока, потому что они образуют оболочку из полисахаридов для плотного сцепления с тканями человека. Присутствует в кишечнике человека и ротовой полости. При создании благоприятных условий (снижение иммунной сопротивляемости) становится причиной развития различных патологий.
Внимание! Клебсиелла – условно-патогенный микроорганизм, который в норме присутствует в кишечнике здорового человека. В небольших количествах следы могут быть обнаружены на слизистых ротовой полости.
В процессе своей активности микроорганизм продуцирует мембранотоксины и энтеротоксины. Подобные вещества разрушают клеточные оболочки. Заражение происходит через дыхательные пути или орально. Источниками инфекции выступают зараженные лица, являющиеся активными носителями. Присутствует вероятность внутриутробного инфицирования плода или заражения в процессе прохождения через родовые пути. Именно поэтому выявление патогена в мазке влагалища или цервикального канала шейки матки в период беременности – опасно.
Продолжительность инкубационного периода 2-5 суток, зависимо от качества работы иммунной системы. Klebsiella pneumoniae распространена в природе и провоцирует развитие патологий не только у человека. Но и у животных. Микроорганизм сохраняет свою активность на предметах быта, в воде и на поверхности грунта. Источником инфекции могут выступать молочные продукты. Способна выживать в холодной среде, чувствительна к санирующим составам, погибает при нагревании.
Клебсиелла окситока не наносит вреда организму человека, в обычных условиях она выступает необходимым компонентом кишечной микрофлоры и органов дыхательной системы. Опасность проявляется из-за снижения иммунитета. Риск развития патологий приходится на весну и осень, энтеробактерии начинают размножаться, их численность увеличивается, прогрессируют воспалительные процессы.
Причиной присутствия клебсиеллы в мазке цервикального канала, уретры или влагалища у женщин выступает несоблюдение основных правил интимной гигиены. Бактерии часто присутствуют в определенных количествах в каловых массах и могут из области ануса попасть на наружные половые органы. Причиной распространения часто выступает анальный секс.
Причины появления клебсиеллы в цервикальном канале
Основной причиной развития патологий, связанных с активностью клебсиеллы, является снижение иммунитета. Предрасположенность имеют лица, относящиеся к следующим группам:
- пациенты с сахарным диабетом, протекающим в стадии декомпенсации;
- лица с авитаминозом;
- страдающие дистрофией;
- люди, имеющие алкогольную или наркотическую зависимость.
Активность условно-патогенных микроорганизмов может значительно усиливаться на фоне использования средств, снижающих иммунитета. Такие препараты применяют после проведения операций по трансплантации органов. Клебсиелла отличается устойчивостью к различным антибактериальным формам, потому не исключено увеличение численности в период приема антибиотиков.
Клебсиелла может выступать в качестве компонента естественной микрофлоры женщины. Но это условие не исключает вероятность заражения. Бактерия проникает в организм человека из-за недостатка гигиены, некачественного мытья овощей и фруктов, при потреблении необработанного коровьего молока или недостаточно приготовленного мяса. Источником инфицирования часто выступает зараженный человек, например, при пневмонии, спровоцированной активность клебсиеллы. Передача происходит воздушно-капельным путем.
Клебсиелла в мазке
Обнаружение клебсиелла в мазке содержимого уретры. Влагалища или цервикального канала – тревожный признак. Женщине стоит уделить внимание своему здоровью, потому что инфицирование указывает на существенное расстройство микрофлоры.
В мазке здоровой женщины такого патогена быть не должно. Его обнаружение свидетельствует о развитии дисбиоза или вагинита и требует своевременного лечения. На фоне активности микроба проявляются различные патологии гинекологического характера. Как и стафилококк, клебсиелла часто вызывает гнойные осложнения.
Чаще всего причина проникновения патогена на слизистые оболочки гениталий – несоблюдение правил личной гигиены. Выявление клебсиеллы в мазке половых органах происходит нередко, потому что область не отличается стерильностью и располагается в непосредственной близости с анальным отверстием, выступающим источником заражения. Если женщина здорова, патогены не развиваются, а погибают сразу после попадания на слизистую. Болезнь развивается при снижении протекции.
Внимание! Клебсиелла особенно опасна для женщин при беременности. Есть риск инфицирования плода и развития послеродового эндометрита. Именно поэтому сдавать мазок в период гестации рекомендуют в каждом триместре. Обследование является обязательным за месяц до родов.
Обнаружение бактерии в мазке цервикального канала свидетельствует о высоком риске развития цистита и пиелонефрита, потому при выявлении патологии необходимо начинать лечение. Инфекционный процесс может спровоцировать развитие сепсиса, представляющего угрозу жизни женщины.
Мазок на микрофлору влагалища нужно сдать при выявлении таких признаков:
- боль в области поясницы, иррадиирующая в бок;
- повышенная температура тела;
- боль и рези при мочеиспускании;
- частые позывы к мочеиспусканию;
- влагалищные выделения, имеющие необычный запах.
Другие характерные симптомы – отсутствуют. В группе риска находятся женщины, пребывавшие в больнице из-за риска заражения внутрибольничным штаммом.
В период беременности
Присутствие клебсиеллы в мазке зева не является нормой в период беременности, но если женщина уделяет достаточное внимание собственному здоровью, что патологию можно обнаружить своевременно и предпринять различные меры для ее устранения. Наиболее высокий риск проявляется в процессе родов, инфекция из влагалища и цервикального канала попадает в матку, где для ее развития и размножения есть питательная среда. Не менее опасно инфицирование младенца при прохождении по родовым путям.
При обнаружении клебсиеллы проводят дополнительное обследование, позволяющее подтвердить результат. Обязательным условием является проведение бактериологического посева мочи, он позволяет исключить риск поражения почек. На основании полученных результатов определяют схему медикаментозной терапии. Если избавиться от заболевания до родов невозможно, проводят операцию кесарева сечения.
Недооценивать опасность такого нарушения – нельзя. Энтеробактер способна влиять на процессы развития плода из-за формирования плода за счет способности провоцировать воспалительный процесс.
Последствия для женщины и ребенка
При выявлении инфекции на раннем сроке беременности, врачи рекомендуют произвести прерывание, чтобы исключить внутриутробное инфицирование. Если женщина отказывается от аборта, обеспечивается лечение. Рекомендован прием антибактериальных препаратов. Их использование в первом триместре не менее опасно и может стать причиной нарушения процесса внутриутробного формирования.
Лечение
Схема лечения определяется в индивидуальном порядке и зависит от тяжести течения болезни у пациента. Чаще всего используют бактериофаги в комплексе с антибиотиками. Подобное лечение не наносит вреда нормальной флоре. В случае неэффективности такого комплекса используют антибактериальные средства. Чаще всего лечение проходит в домашних условиях, госпитализация является крайней мерой и обеспечивается при стремительном ухудшении самочувствия пострадавшего.
Перечень показаний для госпитализации включает:
- длительное повышение температуры тела;
- симптомы острой интоксикации организма;
- признаки сепсиса.
Внимание! Продолжительность лечения зависит от степени поражения.
Как предотвратить инфицирование
Основное правило профилактики инфицирования – соблюдение правил гигиены. Важно мыть потребляемые фрукты и овощи, использовать специальные обеззараживающие растворы при отсутствии возможности вымыть руки с мылом. Нужно уделять внимание поддержке иммунной системы, важно правильно питаться и вести здоровый образ жизни. Медики рекомендуют отказаться от никотиновой зависимости и потребления алкоголя. Пользу принесут прогулки на свежем воздухе, занятия спортом.
Заболевание, спровоцированное клебсиеллой нужно лечить, независимо от того, насколько активно проявляются симптомы патологии. В норме этот микроорганизм должен отсутствовать в мазках женской половой системы, потому его активность опасна, особенно для беременных. Легкие формы у взрослых хорошо поддаются лечению, потому главное – своевременно отреагировать.
Бактериальные посевы позволяют выяснить состав микрофлоры на слизистых оболочках организма. Иногда результаты анализов показывают превышение допустимой концентрации некоторых микробов, что часто случается с Klebsiella pneumoniae. Прежде чем приобретать антибиотики и начинать лечение, важно изучить информацию об этом микроорганизме.
Klebsiella pneumoniae – что это?
Бактерия клебсиелла пневмония еще называется палочкой Фридлендера. Она представляет собой грамотрицательную факультативно-анаэробную коккобациллу. Микроб выглядит как продолговатая палочка с округлыми краями размером 0,6-0,8 на 1-2 мкм. Бактерия Klebsiella pneumoniae неподвижна, спор не образует, но может покрываться капсулой. Располагается одиночно, парно или скоплениями.
Рассматриваемый микроорганизм относится к условно-патогенной флоре. Это значит, что такая палочка в норме обитает на слизистых человека в небольшом количестве. Пока концентрация бактерий не превышает установленных границ, организм остается здоровым. Инфекционное заболевание начинается при бесконтрольном делении и распространении коккобацилл.
Клебсиелла пневмония – пути заражения
Представленный микроорганизм сохраняет жизнеспособность и вне человеческого тела, успешно переносит перепады температур внешней среды. Палочка Фридлендера в виде небольших групп может обитать даже на загрязненных продуктах питания, особенно мясных и молочных. Она передается такими способами:
- воздушно-капельный;
- контактно-бытовой;
- фекально-оральный;
- половой.
Чем опасна Klebsiella pneumoniae?
Увидев в результатах бактериального посева описываемый микроорганизм, не стоит пугаться и начинать прием антибиотиков. Следует вспомнить характеристики Klebsiella pneumoniae, что это такое и какие имеет особенности. Условно-патогенные палочки не несут угрозы, пока их количество остается в пределах установленных норм. Это стандартная составляющая здоровой микрофлоры организма, она может присутствовать в кишечнике, ротовой полости и влагалище, на поверхности кожи.
Инфекционное поражение возникает, когда концентрация бактерий выше определенных границ. Такие случаи характерны для периодов ослабления иммунной системы, что приводит либо к инфицированию заразными формами палочки Фридлендера, либо к патологическому размножению собственных коккобацилл.
Чем опасна клебсиелла пневмония:
- урогенитальные заболевания;
- фиброзные и гнойные плевриты;
- острые гастриты;
- абсцессы селезенки и печени;
- гаймориты;
- воспаление легких;
- эндофтальмиты;
- перикардиты;
- гастродуодениты.
Klebsiella pneumoniae – диагностика
Чтобы выявить указанный микроорганизм, используется три варианта анализов:
- бактериоскопия;
- серологическое исследование;
- бактериальный посев.
Они помогают определить наличие и количество палочек Фридлендера в биологических жидкостях, кале, слизи и массах, выделяемых гнойными очагами. Анализ Klebsiella pneumoniae проводится для:
- мочи;
- мокроты из легких и бронхов, в ротовой полости;
- слизи цервикального канала;
- кала.
Klebsiella pneumoniae – норма
Зная, что представленная коккобацилла присутствует и в абсолютно здоровом организме, необходимо сравнивать полученные результаты исследований с установленными пределами концентрации бактерий. Не во всех анализах может наблюдаться клебсиелла пневмония, норма для некоторых биологических материалов – ноль. Расшифровывать лабораторные исследования самостоятельно сложно, поэтому с результатами лучше сразу отправиться к лечащему доктору.
Клебсиелла пневмония в моче
В этой биологической жидкости рассматриваемый микроорганизм не должен присутствовать. Klebsiella pneumoniae в моче считается патологией, что свидетельствует об инфицировании слизистых оболочек выводящей системы. Заразиться можно половым и контактно-бытовым путем, особенно при несоблюдении правил личной гигиены, использовании чужих полотенец и белья. Существуют разные инфекции, для которых характерно наличие в моче Klebsiella pneumoniae, что это такое в контексте заболеваний:
- кольпит;
- цистит;
- пиелонефрит;
- уретрит;
- гломерулонефрит.
Клебсиелла пневмония в кале
Фекальные массы исследуются для получения или уточнения информации о состоянии микрофлоры слизистых оболочек кишечника и его функционировании. Klebsiella pneumoniae в кале – нормальное явление. В ограниченных количествах она присутствует в системе пищеварения и поддерживает индивидуальный биоценоз, обеспечивая правильную работу иммунитета.
Нормой для описываемой палочки считается концентрация 105 на 1 г биологического материала. Многие современные гастроэнтерологи подчеркивают необходимость трактовки анализа в соответствии с общим самочувствием, особенностями питания и образа жизни. Важно понимать суть количества Klebsiella pneumoniae, что это такое же индивидуальное свойство организма, как цвет глаз или тембр голоса. У каждого человека неповторимая личная микрофлора кишечника, и превышение указанной нормы не всегда свидетельствует о патологии.
Причины говорить о патологии появляются, когда слишком большое количество микробов сочетается со специфическими симптомами. Это сигнализирует об инфекции, что развивается в просвете одного из отделов кишечника. Могут прогрессировать такие заболевания:
- дуоденит;
- колит;
- дисбиоз;
- энтерит;
- синдром раздраженного кишечника;
- болезнь Крона;
- энтероколит.
Клебсиелла пневмония в мазке из зева
В ротовой полости могут присутствовать небольшие колонии рассматриваемой бактерии. Клебсиелла пневмония в горле – нормальное явление. Вдыхая воздух с разреженными частицами, есть вероятность попадания в рот и микроорганизмов. Они задерживаются миндалинами и оседают в слизи, с которой потом выводятся, что препятствует их проникновению в дыхательную систему. Иногда палочки Фридлендера представляют собой часть нормальной микрофлоры оболочек ротовой полости.
Допустимым значением Klebsiella pneumoniae в мазке из зева указывается 105. Если количество коккобацилл существенно превышает указанную норму, могут развиваться такие патологии:
- фарингит;
- тонзиллит;
- стоматит;
- пародонтит;
- ларингит.
Клебсиелла пневмония в мазке из цервикального канала
Присутствие палочек Фридлендера во влагалище тоже считается одним из вариантов нормы. Некоторые женщины ошибочно начинают принимать антибиотики после обнаружения микроорганизма, не уточнив у врача информацию о Klebsiella pneumoniae, что это, почему такое явление наблюдается, и как с ним бороться. Если количество бактерий не выше 105, нет причин для паники. Когда клебсиелла пневмония в мазке слишком концентрирована, следует провести уточняющую диагностику и начинать лечение.
Палочки Фридлендера могут провоцировать разные воспалительные инфекции мочеполовой системы, но особенно они опасны при планировании беременности или в период вынашивания. Klebsiella pneumoniae – что это такое для будущих матерей:
- заражение и гибель плода;
- генетические мутации;
- замирание беременности;
- врожденные аномалии мочевыводящих органов;
- недоразвитие дыхательной системы;
- воспаление легких у ребенка.
Клебсиелла пневмония в крови
Эту биологическую жидкость не сдают для лабораторного исследования на Klebsiella pneumoniae. В крови такие микроорганизмы не выживают, поэтому анализ не будет информативным. Биохимия выполняется только в качестве уточняющего исследования, позволяющего выявить причины ухудшения работы иммунитета и бесконтрольного размножения палочек Фридлендера.
Клебсиелла пневмония – симптомы
Признаки патологического процесса, вызванного представленной коккобациллой, зависят от ее локализации и количества, спровоцированных заболеваний. Поражения мочевыделительной системы характеризуются такими симптомами:
- повышение температуры тела до 38,5 градусов;
- тяжесть в области почек, поясницы;
- жжение или боль во время, в конце мочеиспускания;
- слабость;
- ощущение жажды;
- тупая, постоянная боль в низу живота;
- порционное, прерывистое выделение мочи;
- изменение цвета биологической жидкости;
- резкий запах при походе в туалет;
- примеси в моче (хлопья, сгустки).
Высокая концентрация Klebsiella pneumoniae в кале сигнализирует о кишечных воспалениях, что сопровождается такой клинической картиной:
- метеоризм;
- нарушения стула (диарея, запоры);
- изменение консистенции, однородности и цвета кала;
- боли в животе по ходу кишечника;
- высокая температура тела;
- рвота;
- изжога;
- тошнота;
- ухудшение аппетита.
Большое количество палочек Фридлендера в ротовой полости чревато болью в горле, формированием гнойных очагов в миндалинах, мучительным кашлем и лихорадкой. Гораздо опаснее, если бактериям удалось проникнуть в дыхательные пути. Клебсиеллезная пневмония – одно из частых осложнений инфицирования коккобациллой. После инкубационного периода возникают симптомы, похожие на ОРВИ. Они постепенно усиливаются и дополняются признаками воспаления легких. Пневмония, вызванная клебсиеллой, провоцирует следующую клиническую картину:
- потливость;
- озноб;
- жар;
- одышка;
- сильные приступы кашля;
- выделение гнойной мокроты, иногда – с кровяными сгустками;
- слабость в теле;
- сонливость.
Klebsiella pneumoniae – как лечить?
Тактика терапии подбирается только врачом на основании анамнеза, результатов лабораторных анализов, имеющихся симптомов и предварительного диагноза. В отдельных ситуациях клебсиелла пневмония лечение не предполагает, только динамическое наблюдение. Стандартный способ избавиться от инфекции – прием противомикробных препаратов, но есть и менее сильнодействующие медикаменты, помогающие от бактериального заражения.
Klebsiella pneumoniae – антибиотик
Оптимальным методом подбора таких средств считается тест на чувствительность. Он определяет, как реагирует на разные препараты клебсиелла пневмония, лечение антибиотиками разрабатывается на основе тех медикаментов, которые максимально воздействуют на бактерии. Если такой тест не выполнен, назначаются противомикробные средства широкого спектра активности.
Палочка Фридлендера лечение предполагает следующими медикаментами:
- Офлоксацин;
- Грамокс;
- Амоксициллин;
- Цефалекс;
- Флемоксин Солютаб;
- Амикацин;
- Моксифлоксацин и другие.
Klebsiella pneumoniae – бактериофаг
Этот препарат разработан специально для лечения палочек Фридлендера. Жидкий бактериофаг клебсиелл пневмонии представляет собой стерильный очищенный фильтрат с фаголизатами рассматриваемых микроорганизмов. Он избирательно воздействует на микрофлору слизистых оболочек, уничтожая только патогенные колонии Klebsiella pneumoniae. Бактериофаг можно принимать внутрь, делать с ним клизмы, спринцевания, промывания и полоскания.
Klebsiella pneumoniae – лечение народными средствами
Альтернативная медицина является слабым «противником» для указанных микроорганизмов. Палочка Фридлендера быстро вырабатывает устойчивость даже к сильнодействующим антибиотикам, поэтому народные средства малоэффективны при клебсиеллезе. В качестве поддерживающей терапии можно пить гвоздичный чай, просто добавляя в напиток несколько соцветий этой ароматной специи.